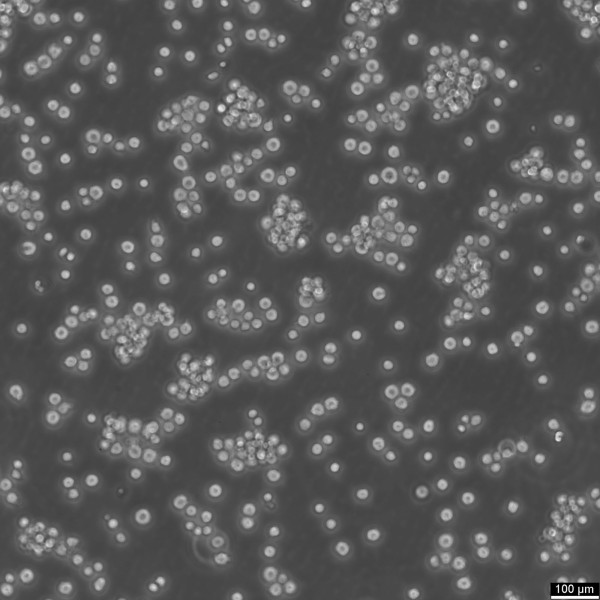
Jurkat Cells

Cookie preferences
This website uses cookies, which are necessary for the technical operation of the website and are always set. Other cookies, which increase the comfort when using this website, are used for direct advertising or to facilitate interaction with other websites and social networks, are only set with your consent.
Configuration
Technically required
These cookies are necessary for the basic functions of the shop.
"Allow all cookies" cookie
"Decline all cookies" cookie
CSRF token
Cookie preferences
Currency change
Customer-specific caching
FACT-Finder tracking
Individual prices
Selected shop
Session
Comfort functions
These cookies are used to make the shopping experience even more appealing, for example for the recognition of the visitor.
Note
Show the facebook fanpage in the right blod sidebar
Statistics & Tracking
Affiliate program
Conversion and usertracking via Google Tag Manager
Track device being used
If you intend to use this Cytion cell line solely for internal research at a single research site, please complete and sign the Material Transfer Agreement (MTA) and submit it along with your order. For any commercial applications – including but not limited to fee-for-service work, quality control testing, product release, diagnostic use, or regulatory studies – please complete the Intended Use Form so we can prepare a suitable agreement tailored to your project.
| Item number | Size | Datasheet | Manual | SDS | Delivery time | Quantity | Price |
|---|---|---|---|---|---|---|---|
| CYT-302147 | 1 each | - |
6 - 10 business days* |
430.00€
|
If you have any questions, please use our Contact Form.
You can also order by e-mail: info@biomol.com
Larger quantity required? Request bulk
You can also order by e-mail: info@biomol.com
Larger quantity required? Request bulk
Categories: Lymphoma cell lines Description: Jurkat cells, which originated from the peripheral... more
Product information "Jurkat Cells"
Categories: Lymphoma cell lines Description: Jurkat cells, which originated from the peripheral blood of a 14-year-old with T-cell acute lymphoblastic leukemia (T-ALL), are a well-known human T lymphocyte cell line commonly used in cell biology studies, particularly in cancer research and immune system disorder investigations. These cells play a crucial role in understanding various cellular processes, including cell death mechanisms, autophagy activity, and cytoplasmic transcription factors. Jurkat cells are commonly used in HIV research due to their expression of the CD4 receptor on their cell membrane. The CD4 receptor is a primary receptor that HIV uses to enter host cells. Because Jurkat cells express this receptor, they can be infected by HIV, making them a useful model for studying HIV's interactions with human T cells, which are a major target of the virus in the human body. The utilization of Jurkat cells in HIV activation and the HIV infection life cycle studies has significantly contributed to understanding the virus's interactions with human cells and has been instrumental in identifying potential targets for antiretroviral therapies. Jurkat cells further play a pivotal role in biomedical research, particularly in the evaluation of cytotoxicity and cell viability assays. This makes them indispensable for testing the effectiveness of potential cancer therapies and agents that modulate the immune response. By employing Jurkat cells, scientists can meticulously analyze the effects of cytotoxic compounds on the integrity and function of the cell membrane, including aspects related to cell membrane permeability and their transport properties. Furthermore, the presence of mutations in the Lck gene within Jurkat cells, which leads to sustained activation of T-cells, provides a unique model for in-depth studies of T-cell activation and signaling pathways. This is essential for understanding the complex processes of lymphocyte activation, which encompasses the cell cycle, cellular growth, and differentiation. Such insights are crucial for developing strategies to modulate immune responses in various diseases. The creation of a specific Jurkat cell derivative, known as Jurkat E6.1, has significantly advanced our comprehension of cellular mechanisms. This derivative offers a refined tool for probing into the nuanced behaviors of cell membranes and the physiological responses of individual cells under experimental conditions. Through the use of Jurkat E6.1 cells, researchers have been able to shed light on fundamental cellular processes and their implications for health and disease. In summary, Jurkat cells serve as invaluable tools in a wide range of research areas, from cancer biology to HIV infection studies, offering insights into cell biology, immune system function, and potential therapeutic interventions. Organism: Human Tissue: Blood Disease: T-cell acute lymphoblastic leukemia Metastatic Site: Peripheral blood Synonyms: JURKAT, JM, JM-Jurkat, Jurkat-FHCRC, Jurkat FHCRC, FHCRC-11, FHCRC subclone 11, FCCH1024 Age: 14 years Gender: Male Ethnicity: European Morphology: Lymphoblast Growth Properties: Suspension Citation: Jurkat (Cytion catalog number 302147) Biosafety Level: 1 Ncbi_ Taxid: 9606.0 Cellosaurus Accession: CVCL_0065 Antigen Expression: Jurkat cells express T-cell receptor (TCR) and CD3 proteins. They also express CD4 and CD8 co-receptors, which aids in identifying them as helper or cytotoxic T cells. Mutational Profile: The Jurkat cell line has been reported to have genetic mutations primarily impacting three core pathways: TCR signaling, genome stability, and O-linked glycosylation. In TCR signaling, mutations in PTEN, INPP5D, CTLA4, and SYK disrupt normal cellular responses to T-cell receptor activation, potentially affecting proliferation and survival. Genome stability is compromised by mutations in TP53, BAX, and MSH2, leading to impaired DNA repair mechanisms and an increased susceptibility to tumorigenesis. Additionally, a mutation in C1GALT1C1 disrupts O-linked glycosylation processes, resulting in the expression of truncated O-glycans [1]. Additionally, the Jurkat cells have a point mutation in the Lck gene, which encodes a protein necessary for T-cell activation, causing T cells to be constitutively activated. References: 1. Gioia, L., Siddique, A., Head, S. R., Salomon, D. R., & Su, A. I. (2018). A genome-wide survey of mutations in the Jurkat cell line. BMC genomics, 19, 1-13. Karyotype: The Jurkat cell line is hypotetraploid with a flat modal karyotype of 46 chromosomes and 7.8% polyploidy. Culture Medium: RPMI 1640, w: 2.0 mM stable Glutamine, w: 2.0 g/L NaHCO3 (Cytion article number 820700a) Supplements: Supplement the medium with 10% heat-inactivated FBS Doubling Time: 26 hours Subculturing: Gently homogenize the cell suspension in the flask by pipetting up and down, then take a representative sample to determine the cell density per ml. Dilute the suspension to achieve a cell concentration of 1 x 105 cells/ml with fresh culture medium, and aliquot the adjusted suspension into new flasks for further cultivation. Fluid Renewal: 2 to 3 times per week Freeze Medium: As a cryopreservation medium, use complete growth medium (including FBS) + 10% DMSO for adequate post-thaw viability, or CM-1 (Cytion catalog number 800100), which includes optimized osmoprotectants and metabolic stabilizers to enhance recovery and reduce cryo-induced stress. Thawing And Culturing Cells: Confirm that the vial remains deeply frozen upon delivery, as cells are shipped on dry ice to maintain optimal temperatures during transit. Upon receipt, either store the cryovial immediately at temperatures below -150°C to ensure the preservation of cellular integrity, or proceed to step 3 if immediate culturing is required. For immediate culturing, swiftly thaw the vial by immersing it in a 37°C water bath with clean water and an antimicrobial agent, agitating gently for 40-60 seconds until a small ice clump remains. Perform all subsequent steps under sterile conditions in a flow hood, disinfecting the cryovial with 70% ethanol before opening. Carefully open the disinfected vial and transfer the cell suspension into a 15 ml centrifuge tube containing 8 ml of room-temperature culture medium, mixing gently. Centrifuge the mixture at 300 x g for 3 minutes to separate the cells and carefully discard the supernatant containing residual freezing medium. Gently resuspend the cell pellet in 10 ml of fresh culture medium. For adherent cells, divide the suspension between two T25 culture flasks, for suspension cultures, transfer all the medium into one T25 flask to promote effective cell interaction and growth. Adhere to established subculture protocols for continued growth and maintenance of the cell line, ensuring reliable experimental outcomes. Sterility: Mycoplasma contamination is excluded using both PCR-based assays and luminescence-based mycoplasma detection methods. To ensure there is no bacterial, fungal, or yeast contamination, cell cultures are subjected to daily visual inspections. Safety Precautions: When planning to store a cryovial in liquid nitrogen for future thawing, it is mandatory to adhere to stringent safety measures. Appropriate protective gloves and clothing are essential, and the use of a face mask or safety goggles is required during the transfer of frozen samples to or from the liquid nitrogen tank. This is to mitigate the risk of injury from potential cryovial explosions upon removal, which can result in the projection of sharp fragments. Warranty: We stand by the promise of delivering products with high cell viability and robust culture performance. To achieve the best results, please make sure you follow the storage and culture instructions detailed in the product information sheet closely. Your adherence to these guidelines is key to success. Subject To Material Transfer Agreements: If you intend to use Cytion cell lines solely for internal research at a single research site, please complete and sign our Material Transfer Agreement (MTA) and submit it along with your order.For any commercial applications - including but not limited to fee-for-service work, quality control testing, product release, diagnostic use, or regulatory studies - please complete the Intended Use Form so we can prepare a suitable agreement tailored to your project.Please note: The MTA applies only to certain cell lines. If this notice and the MTA document appear on a product page, the agreement is applicable. For cell lines not covered by the MTA, no reference to the agreement will be shown. The MTA is not valid for customers in the Americas, China, or Taiwan. Please contact our U.S. entity to receive the appropriate agreement. Required Product 1: 820700a Required Product 3: 860015.0 Required Product 4: 830100.0
| Supplier: | Cytion |
| Supplier-Nr: | 302147 |
Properties
| Application: | Peripheral blood |
| Species reactivity: | human |
Database Information
Handling & Safety
| Storage: | Liquid nitrogen |
| Shipping: | -80°C (International: -80°C) |
Caution
Our products are for laboratory research use only: Not for administration to humans!
Our products are for laboratory research use only: Not for administration to humans!
You will get a certificate here
Viewed